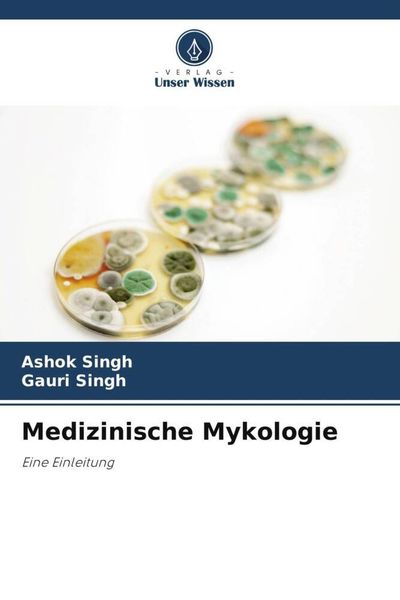
Medizinische Mykologie, Taschenbuch von Ashok Singh , Gauri Singh, Verlag Unser Wissen, 9786207395385

Alu-Dibond Bild ️ Leopard in der Dunkelheit | Quadrat | wandbild.com 180 x 180
€899.00
inkl. MwSt. zzgl. Versand

2 Zimmermann Bremsscheiben 324mm vorne für Renault Vel Satis Expace IV
€138.77
inkl. MwSt. zzgl. Versand
Versand: €15.00

Maison Exclusive - Boxspringbett mit Matratze Weiß 90x200 cm Kunstleder
€577.95
inkl. MwSt. zzgl. Versand
Versand: €0.00

Gallantry, Gesteppte Damen Schultertasche mit goldener Kette und Drehverschluss, Blau
€44.90
inkl. MwSt. zzgl. Versand
Versand: €9.90

MuchoWow - Wierderverwendbar - Selbstklebend
€24.99
inkl. MwSt. zzgl. Versand
Versand: €0.00

new balance Rövid szárú sportcipők '740' Férfi szürke , Méret 9
HUF 46,990.00
inkl. MwSt. zzgl. Versand

Schaftfräser S524 D.3mm R.0,3mm Gesamt-L.75mm Schneiden-L.5mm
€81.28
inkl. MwSt. zzgl. Versand
Versand: €7.19

Maximilian Equestrian Turniershirt Damen Aira, kurzarm
€89.90
inkl. MwSt. zzgl. Versand
Versand: €0.00

Teyli Mesh Slip mit floraler Spitze Glamour Female 312 rot 3XL
€14.99
inkl. MwSt. zzgl. Versand
Versand: €0.00

BEMM Design-Heizkörper Sammelrohre rechts „ChaCha MN“ 60 × 118,9 cm in Sand perlmatt
€810.02
inkl. MwSt. zzgl. Versand
Versand: €69.00

Allgemeine Kulturgeschichte von der Urzeit bis auf die Gegenwart
€99.90
inkl. MwSt. zzgl. Versand
Versand: €0.00

El Naturalista Sandalen Herren/Damen N5860 PLEASANT WOOD / TABERNAS Farbe Braun
€100.00
inkl. MwSt. zzgl. Versand
Versand: €0.00

ARTland Wandbild, selbstklebend Wollgras weiße Schneebälle im Moor Größe: 60x40 cm
€29.90
inkl. MwSt. zzgl. Versand
Versand: €0.00

Beste Selbstachtung - klassische Übungen - Frédéric Garnier, Audio, 9782821167681
€4.90
inkl. MwSt. zzgl. Versand
Versand: €0.00

MuchoWow Textilposter Schmetterling - Blume - Insekt 90x45 cm mit schwarzem Rahmen - Klemmleisten
€34.95
inkl. MwSt. zzgl. Versand
Versand: €0.00

OneMillionCanvasses - Leinwandbilder - 150x100 cm, Linie - Pastell - Abstrakt - Muster, Wandbilder Kunstdruck Wanddekoration - Foto auf Leinwand ...
€99.95
inkl. MwSt. zzgl. Versand
Versand: €0.00

kwb 3-tlg. Holzbohrer-Set lang - 6 mm, 8 mm, 10 mm - Extra lange Bohrer für präzise Bohrungen in Holzbalken - CV-Stahl, Industriequalität
€4.18
inkl. MwSt. zzgl. Versand
Versand: €5.95

Tescoma Suppenteller CREMA ø 22 cm
€12.39
inkl. MwSt. zzgl. Versand
Versand: €0.00

MASCOT Warnschutz-Hose mit Knietaschen - Schwarzblau/Hi-vis Orange - 76C56
€138.49
inkl. MwSt. zzgl. Versand

Adidas Predator League Fg/Mg Navy
€97.00
inkl. MwSt. zzgl. Versand

Vans MN Filmore VN0A3MTJT2J1 (41/black-pewter)
€61.12
inkl. MwSt. zzgl. Versand
Versand: €0.00

Acrylglasbild "Das Schloss in Rotenburg" artboxONE - Architektur
€59.99
inkl. MwSt. zzgl. Versand
Versand: €4.99

Poster - Poster ohne Rahmen - Blau Kaktus Blume - 40x40 cm - Wand Bild - Wanddeko - Wandbilder - Kunstposter - Wandposter - Bilder - Kunstdruck - W...
€16.99
inkl. MwSt. zzgl. Versand
Versand: €12.99

Poster mit schwarzem Rahmen "Wundervolles Bagan" artboxONE - Architektur,Reise / Asien
€24.99
inkl. MwSt. zzgl. Versand
Versand: €4.99

The Cribs: The Cribs (Definitve Edition) (2 CDs)
€16.99
inkl. MwSt. zzgl. Versand
Versand: €2.99

Plato: A Complete Introduction: Teach Yourself
€23.47
inkl. MwSt. zzgl. Versand
Versand: €0.00

Geometrische Fliesenmuster – Selbstklebend – Wandverkleidung – Wandpaneel – Wanddeko – Dekorative Wandpaneele – 3D Wandpaneele – Wand...
€44.99
inkl. MwSt. zzgl. Versand
Versand: €0.00

BLIC Stoßstange Stoßfänger für OPEL Astra K Sports Tourer (B16) 5510-00-5056901Q
€212.68
inkl. MwSt. zzgl. Versand
Versand: €0.00

Beistellbett mit matratze,Babywiege Stubenwagen Reisebett Kinderbett Höhenverstellbar 92x58x70-90cm Schwarz
€83.53
inkl. MwSt. zzgl. Versand
Versand: €0.00

La petite menteuse
€20.44
inkl. MwSt. zzgl. Versand
Versand: €1.90

Covalliero Kartusche für Airbag Weste Manege, Ersatzteil
€24.99
inkl. MwSt. zzgl. Versand
Versand: €4.98

Schmidt Spiele 1.000tlg. Puzzle "Süße Welpenszene" - ab 14 Jahren - 12% | Gesellschaftsspiele
€15.99
inkl. MwSt. zzgl. Versand
Versand: €4.95

Fußballplatz Schild mit Pfeil rechts A3 Rückseite selbstklebend
€29.99
inkl. MwSt. zzgl. Versand
Versand: €0.00

Alu-Dibond Bild ️ Verborgene Schönheit | Schmal | BigBilder 40 x 100
€169.00
inkl. MwSt. zzgl. Versand

ABAKUHAUS Libelle Bettbezug, Kinder-Cartoon Thema, Milbensicher Allergiker geeignet mit Kissenbezügen, 155 cm x 220 cm - 80 x 80 cm, Lime Green Bl...
€38.99
inkl. MwSt. zzgl. Versand
Versand: €0.00

El lobo de mar
€18.89
inkl. MwSt. zzgl. Versand
Versand: €0.00
Camper Low-Top-Sneaker - Sneaker Pelotas Ariel Hella Twins - Gr. 42 (EU) - in weiß - für Damen - Leder
€250.00
inkl. MwSt. zzgl. Versand
Medizinische Mykologie, Taschenbuch von Ashok Singh , Gauri Singh, Verlag Unser Wissen, 9786207395385
€43.90
inkl. MwSt. zzgl. Versand
Versand: €0.00

Grammer MSG 85 Gurtband kpl. 133923
€63.19
inkl. MwSt. zzgl. Versand

1/4" x 1/8" Barbed Reduction Tee, white polypropylene
€3.08
inkl. MwSt. zzgl. Versand
Versand: €9.52

Mira Holz Bilderrahmen Merlines 27x48 cm Hellbraun
€55.25
inkl. MwSt. zzgl. Versand

GÖZZE Fertigvorhang DEVIN weiß BH 140x245 cm weiß Gardine
€24.90
inkl. MwSt. zzgl. Versand
Versand: €6.90

Sauna-Massage-Salz Kaktusfeige 1000 g Dose
€15.05
inkl. MwSt. zzgl. Versand
EG–AVersand: €5.95

Der Fundhund / Silbenhilfe. Begleitmaterial - Ramona van Zadel (Buch)
€15.95
inkl. MwSt. zzgl. Versand
Versand: €0.00

Huuraa Damen Polo Shirt Taipei my love XS Black Bio Baumwolle Fairtrade Poloshirt Geschenkidee
€44.99
inkl. MwSt. zzgl. Versand
Versand: €0.00

Künstlicher Rosenbaum - Bodenstehende Kunstpflanze 120 cm - Realistische Blüten - Grüne Blätter - Für Außenbereich - PVC - Tiefrosa
€80.99
inkl. MwSt. zzgl. Versand
Versand: €0.00

5x Widerstandsnetzwerk: X Anz.Widerstand: 8 100Ω THT 0,125W 2% RNLA09G0101B0E Widersts
€7.98
inkl. MwSt. zzgl. Versand
Versand: €0.00
Lumisky TWINS Kabellose Tischleuchte H16CM Stahl Terrakotta
€23.50
inkl. MwSt. zzgl. Versand
Versand: €3.57

hoftronic Ramsay LED Bodeneinbaustrahler 4W 345lm 6500K IP67 Edelstahl 9er Set
€203.22
inkl. MwSt. zzgl. Versand
FG–AVersand: €0.00

Caisley PRIMAFLEX - Cartellini auricolari misura 2 - 61x45mm 251-275 giallo
€17.39
inkl. MwSt. zzgl. Versand

Herren Grafik T-Shirt Sommerliches Surfen in Peniche – Summer Time Surf In Peniche – Öko-Verantwortlich Vintage Jahrgang Kurzarm Lustige Druck
€22.95
inkl. MwSt. zzgl. Versand
Versand: €4.95

How to kill a company - Michael Hampel, Audio, 4069828037076
€15.95
inkl. MwSt. zzgl. Versand
Versand: €0.00

Polsterbett PORTO mit Kopfteil, 180x200 cm, Doppelbett mit Bettkasten und Lattenrost aus Metal, Velourstoff Rosa
€758.00
inkl. MwSt. zzgl. Versand
Versand: €0.00

MuchoWow Wandteppich Wandbehang Eine Bäuerin mit Kühen auf einer Landstraße im Regen - Gemälde von Anton Mauve 150x100 cm Tapisserie Dekorati...
€89.95
inkl. MwSt. zzgl. Versand
Versand: €0.00

Sektgläser Sektglas Viola Stone matt geschliffen 190 ml 6er Set Bohemia Kristallglas Crystalex
€55.99
inkl. MwSt. zzgl. Versand
Versand: €6.99

Mr. & Mrs. Panda Kerze Hummel Blume 19 x 8 cm - Weiß - Geschenk, Erinnerungskerze, Hummeln, Biene, Blockkerze, Natur, Bedruckte, Erinnerungslicht,...
€25.49
inkl. MwSt. zzgl. Versand
Versand: €4.90

METZGER Türfeststeller 2312205
€20.65
inkl. MwSt. zzgl. Versand

Beitrag zu einer Geschichte der dramatischen Einheiten in Italien
€109.95
inkl. MwSt. zzgl. Versand
Versand: €0.00

Maximex Profi Nähahle Set
€12.95
inkl. MwSt. zzgl. Versand
Versand: €2.95

iPhone 13 Pro Glas - 3 Stück
€23.99
inkl. MwSt. zzgl. Versand
Versand: €0.00

16GB 2133 2Rx8 HP 14 14-bw007ng RAM Upgrade Arbeitsspeicher
€154.94
inkl. MwSt. zzgl. Versand
Versand: €5.90

Kiwistar - Autoaufkleber - Portuguese water dog Hund - Neongrün - 50x45cm - Aufkleber für Auto, Laptop, Fahrrad, LKW, Motorrad mehrfarbig JDM Dec...
€18.99
inkl. MwSt. zzgl. Versand
Versand: €1.00

MuchoWow Wandtattoo Wandsticker Wandaufkleber Marmor - Textur - Grau 80x60 cm Selbstklebend und Repositionierbar - Faltenfrei
€32.99
inkl. MwSt. zzgl. Versand
Versand: €0.00

Alu-Dibond Bild ️ Frostiger Wald | Schmal | wandbild.com 80 x 200
€479.00
inkl. MwSt. zzgl. Versand

Scott Junior Shorts black/dark grey L (152)
€49.49
inkl. MwSt. zzgl. Versand
Versand: €0.00

DIE SEELE IM JENSEITS. Erleuchtung geschieht, wenn von uns nichts als Liebe übrig ist, Gebundene Ausgabe von Whitley Strieber,Anne Strieber, AMRA
€22.99
inkl. MwSt. zzgl. Versand
Versand: €0.00

E90SP D32-03-W25-10 - Iscar - HELIQUAD - Modulares Fräsen mit Wendeplatten
€396.00
inkl. MwSt. zzgl. Versand

MuchoWow Mülltonnenaufkleber Toskana - Rosen - Hügel 44x98 cm - Containeraufkleber - Aufkleber - Mülltonnen-Aufkleber
€21.95
inkl. MwSt. zzgl. Versand
Versand: €0.00

vhbw 10x Staubbeutel kompatibel mit BVC C 600, Compact 600, Junior, Junior Super, S 500, S 600, S 700, S 800 Staubsauger - 34cm x 33cm Weiß
€21.99
inkl. MwSt. zzgl. Versand
Versand: €0.00

Mineralguss-Duschwanne extra flach DEXA Schieferoptik ANTHRAZIT 70x150 cm Ablaufschutz in Chrom
€419.99
inkl. MwSt. zzgl. Versand
Versand: €44.99

Poster ️ Florales Frauenporträt - Erika | Schmal | wandbild.com 20 x 50
€39.00
inkl. MwSt. zzgl. Versand

Bench Boxer 4 -teilig bordeaux, schwarz, anthrazit-meliert, navy Größe M
€34.00
inkl. MwSt. zzgl. Versand
Versand: €0.00

Flohsamen ganz 100 g
€4.57(€45,700.00 / kg)
inkl. MwSt. zzgl. Versand
Versand: €3.99

Acrylglasbild ️ Bär & Häschen | Querformat | wandbild.com 40 x 30
€89.00
inkl. MwSt. zzgl. Versand
Tehalit Verbinderset KTSAV00(VE10)
€78.52
inkl. MwSt. zzgl. Versand
Versand: €6.99

SANTRAS Waschtischarmatur Magis in Weiß (RAL 9003)
€129.99
inkl. MwSt. zzgl. Versand
Versand: €0.00

Neodym Magnete 13 x 7 x 2 mm N38 Quader Case - 10 Stück, Extrem stark, Magnettafeln, Kühlschränke, Whiteboards, DIY
€1.69
inkl. MwSt. zzgl. Versand
Versand: €6.50
Plein Sport - Tanktop - Größe M - schwarz
€89.99
inkl. MwSt. zzgl. Versand

Wallario Ordnerrücken Sticker, selbstklebend für schmale Ordner, 12 Stück, Motiv Orangene Rosenblüten im Strauß
€19.95
inkl. MwSt. zzgl. Versand
Versand: €0.00

Ich, was ich mag...
€11.55
inkl. MwSt. zzgl. Versand
Versand: €0.00

HSK K2P Drehtür und Nebenteil in Nische 90 x 200 cm
€1,150.47
inkl. MwSt. zzgl. Versand

TENG TOOLS Steckschlüssel TX E22 1/2 CrV 112070800
€6.57
inkl. MwSt. zzgl. Versand
Versand: €10.00

SKINSTAR Schneeschuhe Alu-Rahmen Schneeschuhwandern Allround bis 130kg orange - Groesse: 30 INCH
€99.99
inkl. MwSt. zzgl. Versand
Versand: €4.90

Tales of Married Life - T. S. Arthur (Buch)
€69.90
inkl. MwSt. zzgl. Versand
Versand: €0.00

Skechers WIP 303882L-NVMT in Navy Sparkle Mesh/Multi Trim color size 30
€38.99
inkl. MwSt. zzgl. Versand
Versand: €4.99

Vor der Ewigkeit - Hubert Gaisbauer (Buch)
€26.00
inkl. MwSt. zzgl. Versand
Versand: €0.00

Waldhausen Health + Care Halsteil Ice Layer Neck Cover Nachtblau Full | kavalio - für mich und mein Pferd
€34.95
inkl. MwSt. zzgl. Versand
Versand: €5.99

NAEMI Handtasche Damen Größe One Size blue denim / gold
€159.95
inkl. MwSt. zzgl. Versand
Versand: €0.00

Lüke Schuhe ADELE LEGNO, Slipper & Mokassin in Braun für Damen, Größe 39
€129.90
inkl. MwSt. zzgl. Versand

MYLAVIE by Sarah Harrison Kardigán Női narancs , Méret XS
HUF 20,490.00
inkl. MwSt. zzgl. Versand

Für Kawasaki Kx 250 '91 Kdx 250 '91-'93 Kupplungsscheiben
€72.52
inkl. MwSt. zzgl. Versand
Versand: €8.99

Ibanez GRG320FA-TVT E-Gitarre
€399.00
inkl. MwSt. zzgl. Versand
Versand: €0.00

VELUX Original Verdunkelungsrollo für VELUX dachfenster PK08, Dunkelblau, weißer Führungsschiene
€121.92
inkl. MwSt. zzgl. Versand
Versand: €0.00

Mende Frames Holz Wandspiegel Galet 40x60 cm Weiß
€52.65
inkl. MwSt. zzgl. Versand

4x Reifendrucksensoren RDKS Sensoren Metallventil Silber für Toyota Land Cruiser 79 2015-2019
€74.89
inkl. MwSt. zzgl. Versand
Versand: €0.00

DFV mobile - Etui für HOMTOM H5 (2018) Gehäusedeckelgürtel aus Nylon mit Zwei Vertikalen und Horizontalen Gürtelschlaufen, E0-7DG-N-FvhOXF-432
€19.95
inkl. MwSt. zzgl. Versand
Versand: €0.00

MuchoWow Wandteppich Wandbehang Ich liebe - Rosalie - Mädchen 60x60 cm Tapisserie Dekoration Wandtuch - Dekorationen - Wand Decke
€38.95
inkl. MwSt. zzgl. Versand
Versand: €0.00

PSSO DMX Kabel IP65 3pol 7,5m sw
€58.31
inkl. MwSt. zzgl. Versand
Versand: €5.90

dbramante1928 Capri Handy-Schutzhülle 17 cm (6.7") Cover Mehrfarbig
€31.81
inkl. MwSt. zzgl. Versand
Versand: €0.00

MXS084/3 EBC Goldstuff Rennbremsbeläge
€36.55
inkl. MwSt. zzgl. Versand
Versand: €4.90
